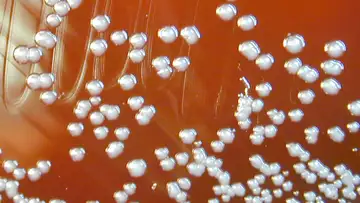

Unexplained, Contagious ComasConstant Wonder • Season 2022, Episode 1195, Segment 1
Sep 28, 2021 • 38m
Since the late 90s, a number of refugee children in Sweden have fallen victim to a mysterious “resignation syndrome” that renders them immobile and unresponsive. Why illnesses like these are real and how the mind and body work in tandem to call for help.
Guest: Suzanne O’Sullivan, author of "The Sleeping Beauties and Other Stories of Mystery Illness"